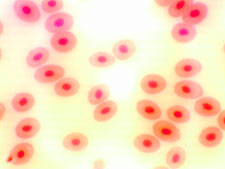
Microscope image, frog's blood, 1000x

|
The images found below were all captured with a 3.1 mega pixel microscope digital camera. All images shown below were compressed to load faster on your computer, but are otherwise untouched photos.
Images taken using a 3.1 mega pixel digital camera on the ML7100 Metallurgical Microscope.
The images were captured with a digital student microscope.
|